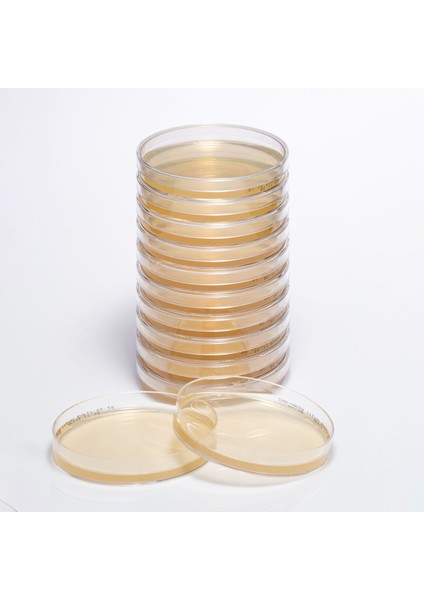
Hazır Chromogenic Mrsa Besiyeri - 1 Paket (10 Adet)

Medexia Company Hazır Chromogenic Mrsa Besiyeri - 1 Paket (10 Adet)
Henüz değerlendirilmemişİlk sen değerlendir
Satıcı: Medexia Company
9,5
9,5Satıcı puanı
Satıcı puanı, müşteri geri bildirimleri ve satıcının sipariş sürecindeki performansı dikkate alınarak hesaplanmaktadır.Ürün Bilgileri
Yurt Dışı Satış
Yok
Stok Kodu
HBCV0000AZUQPT
Stok Adedi
10.000 adetten az
Hazır Chromogenic Mrsa Besiyeri - 1 Paket (10 Adet)
nullÜrün özellikleri
Yurt Dışı Satış
Yok
Stok Kodu
HBCV0000AZUQPT
Stok Adedi
10.000 adetten az
Hatalı içerik bildir
Popüler Aramalar